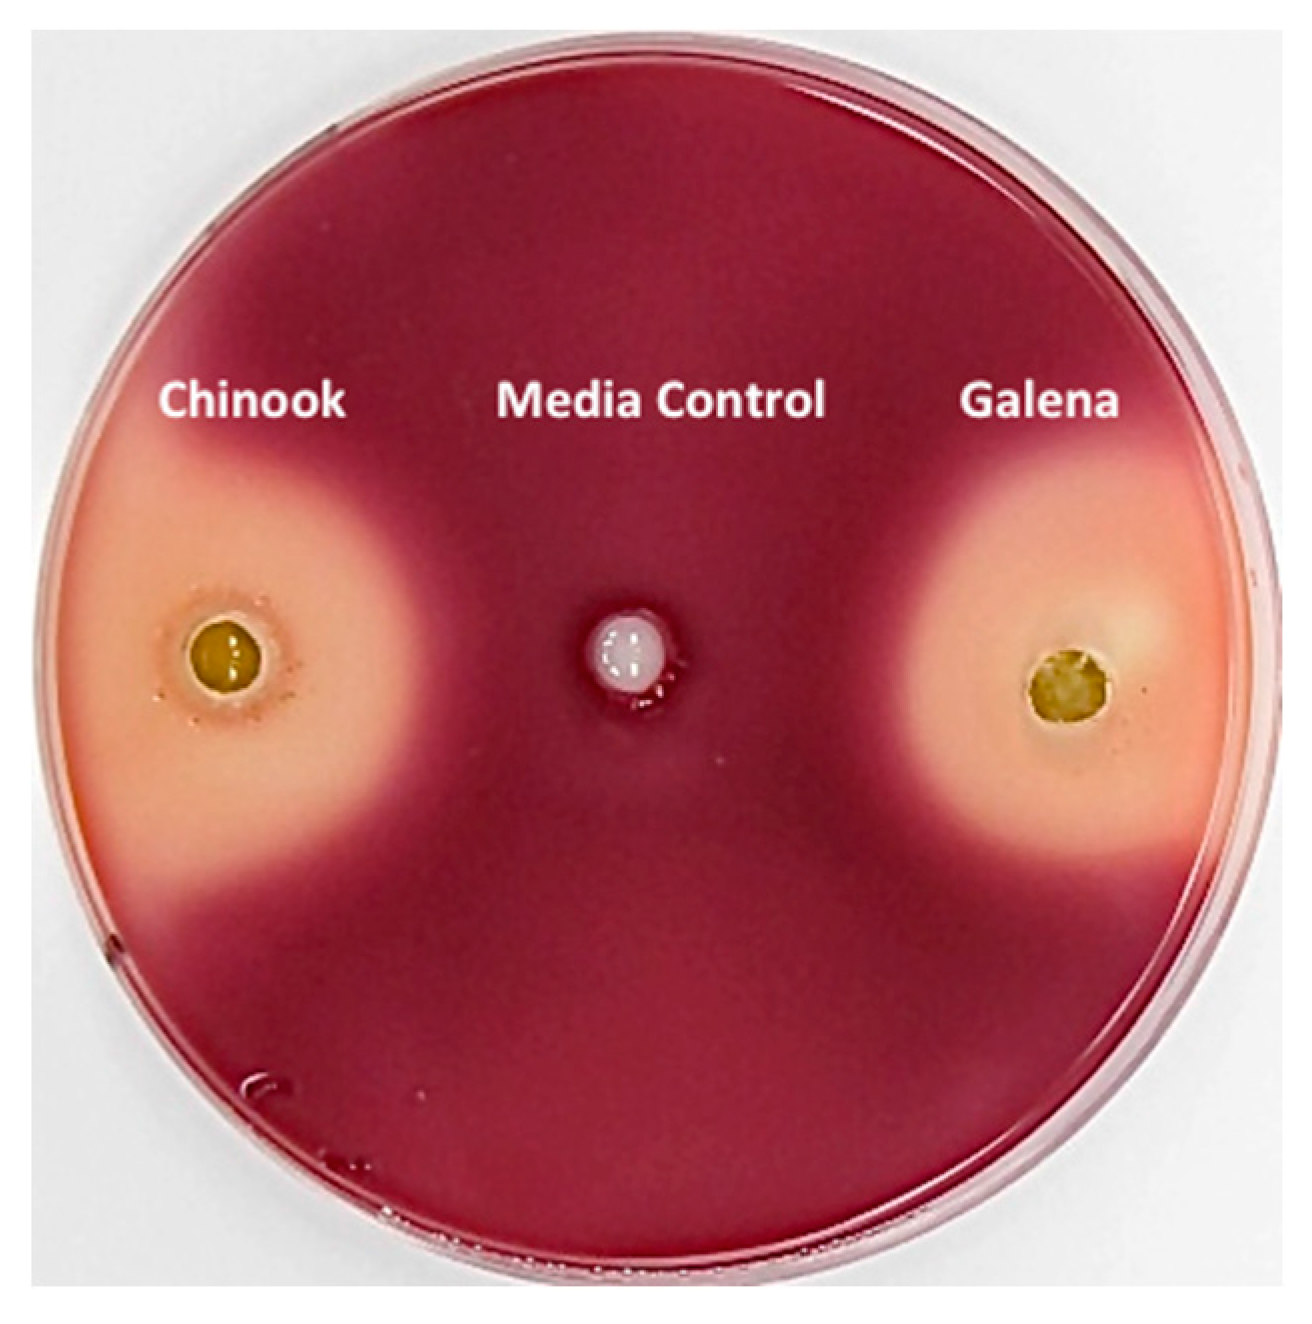
Fermentation 03 00068 g002

Abstract
Surplus hops (Humulus lupulus L.) that are not needed by the brewing industry could be used as a feed supplement for cattle and other ruminants. Previous research indicates that antimicrobial hops plant secondary metabolites (i.e., α- and β-acids) inhibit methane and ammonia production and promote the growth of ruminant animals. The goal was to determine that hop pellets produced for brewing still possessed the requisite antimicrobial activity after 5-year storage. HPLC (high performance liquid chromatography) analysis indicated that the α- and β-acid concentrations in two varieties of hops were relatively stable after 5 years of storage under N2. Either hop variety inhibited the growth of the ruminal hyper ammonia-producing bacterium, Clostridium sticklandii SR, in broth culture and Petri plate bioassays. Either hop variety inhibited ammonia production from amino acids or peptides by mixed rumen microorganisms from Holstein steers. These results are similar to those previously obtained with fresh hops, hops extracts, other antimicrobial phytochemicals and typical feed ionophores, such as monensin. The rumen-active antimicrobial phytochemicals in hops can still be present and active after years under certain storage conditions. Further investigation is warranted to determine how surplus and older hops can be used to benefit ruminant nutrition and ruminant industries.
1. Introduction
Beer, particularly beer with high hop content, has become popular in the United States. Increased demand for hops has led to increased production, and the land used for hop production in the U.S. has increased from approximately 29,000 to 54,000 acres from 2012 to 2016 [1]. The increase in production led to a surplus and a need to find alternative markets for hops.
Ruminant feed supplementation is one alternative use for hops [2]. The rumen, the first digestive compartment of a ruminant animal, is the site of extensive fermentation of feedstuffs. Hundreds of species of bacteria, archaea and protists digest the feed before continuing through the gastrointestinal tract. Bacterial fermentation is required to metabolize the fiber, but like any industrially important fermentation, we optimize it. Ruminants are often fed non-therapeutic/prophylactic (e.g., tetracyclines, macrolides) or clinically irrelevant (e.g., ionophores) antibiotics to selectively inhibit particular fermentation products, such as methane and ammonia [3]. Methane is eructated and most of the ammonia is lost in the urine. When these losses of carbon and nitrogen are inhibited, animals gain weight more efficiently.
It has been proposed that a number of the benefits of feed antibiotics could be achieved with antimicrobial plant secondary metabolites, like the bitter acids in hops (e.g., the humulones and lupulones, called α- and β-acids, respectively). Research results indicate that hops could: decrease methane production [4], ameliorate rumen acidosis [5], decrease proteolysis [6] and decrease deamination of amino acids to ammonia [7]. Taken together, these factors lessen the environmental impacts of cattle production, and improve feeding efficiency, animal performance and wellbeing.
The current study was undertaken to determine if older hops (stored under nitrogen), which might be less desirable to brewers, still have the antimicrobial activity that makes them useful in ruminant diets. We examined the α- and β-acid content in two hop variety pellets that were stored for 5 years under N2 in refrigeration. Then antimicrobial activity was evaluated in two assays that are related to rumen nitrogen efficiency. The hypothesis was that as long as the bitter acids were still present in the pellets, then they would still have the desired activity.
2. Materials and Methods
2.1. Hops and Bitter Acid Extraction
Galena and Chinook type 90 hop pellets were from the 2012 crop. They were stored vacuum-sealed under nitrogen in polyethylene terephthalate foil bags in refrigeration (approx. 4 °C). Moisture content was determined by weighing samples (1 g) before and after oven-drying to stable weight (48 h, 65 °C). Pellets were only dried for moisture content. The pellets extracted for HPLC were not dried.
The extraction and analysis were based on a modification of two previous published protocols [8,9]. Individual pellets were placed in separate glass beakers with a magnetic stir bar, and 10 mL of extraction solvent (0.05% phosphoric acid in methanol) was added to each. The outside of the container was covered in foil to protect contents from light, and the top was covered with Parafilm to decrease evaporation. Contents were kept at room temperature for 4 h with occasional agitation on a magnetic stirrer. The beakers were then sonicated in cold water for three 15-second bursts and then clarified by centrifugation (5150× g, 10 min, 4 °C). Supernatant was placed in a separate container and covered with foil, and 3 mL of extraction solvent was added to the pellet residue. The pellet was vortexed for 2 min and centrifuged as above. The supernatant was removed and combined with the previous supernatant fraction in a 50-mL conical tube, where extraction solvent was added to each hops sample in order to reach a final volume of 20 mL. The tubes were then covered with foil and placed at 4 °C overnight. Prior to HPLC analysis, 4.5 mL were filtered through a 0.2 µm Nylon syringe filter (Grace Davison Discovery Sciences, Deerfield, IL, USA).
2.2. Bitter Acid Quantification
The hops standard, which was obtained from the American Society of Brewing Chemists (ASBC) (St Paul, MN, USA), was the International Calibration Extract 3 (ICE-3). ICE-3 is a de-oiled CO2 hop extract containing: total α-acids 44.64% (cohumulone 13.88%, n- + adhumulone 30.76%), total β-acids 24.28% (colupulone 13.44%, n- + adlupulone 10.84%).
The procedure for diluting the ICE-3 for a standard curve was followed directly from the ASBC. Briefly, 0.5 g of the standard was diluted with 100 mL of extraction solvent (see Section 2.1). Samples (10 mL) were removed and diluted with an additional 50 mL of extraction buffer. This dilution, which was used as the most concentrated standard for the calibration curve, was filtered through a 0.2 µm Nylon syringe filter prior to further dilution. The standard curve contained 8 serial dilutions.
The standards and samples were analyzed on a Summit HPLC (Dionex, Sunnyvale, CA, USA) with a P680 pump and Ultimate 3000 UV detector at 314 nm, operated with Chromeleon 6.8 software (Dionex, Sunnyvale, CA, USA). A Phenomenex (Torrance, CA, USA) Luna 5 µm C18 250 mm × 4.6 mm column and C18 guard column were used in the analysis. The isocratic solvent system consisted of two solvents: solvent A (0.05% phosphoric acid in methanol) and solvent B (0.1% phosphoric acid in water). Both solvents were filtered and degassed, and a constant ratio of solvent A to solvent B (90:10) was maintained. Flow rate was 1.5 mL min−1; column temperature was 30 °C; and duration of each sample run was 20 min. Standards were injected at the beginning, middle and end of each set of sample injections in order to verify retention times, which shifted over time.
2.3. Medium Composition and Culture Conditions
Basal medium was similar to one described by Chen and Russell [10], and contained (per liter): 240 mg KH2PO4, 240 mg K2HPO4, 480 mg NaCl, 480 mg (NH4)2SO4, 100 mg MgSO4·7H2O, 64 mg CaCl2·2H2O, 600 mg cysteine hydrochloride. The broth also contained 10 mL vitamin solution (per liter in 0.1 M K2HPO4: 100 mg pyradoxamine 2HCl, 200 mg riboflavin, 200 mg thiamine HCl, 200 mg nicotinamide, 200 mg CaD pantotheinate, 100 mg lipoic acid, 100 mg pyridoxal HCl, 100 mg pyridoxine, 10 mg p-aminobenzoic acid, 5 mg folic acid, 5 mg biotin, and 5 mg cobalamin) and 5 mL Pfennigs’ trace mineral solution (per liter: 500 mg Na4EDTA, 200 mg FeSO4∙7H2O, 200 mg MnCl2∙4H2O, 20 mg H3BO3, 20 mg CoCl2∙6H2O, 10 mg ZnSO4∙7H2O, 3 mg Na2MoO4∙2H2O, 2 mg NiCl2∙6H2O, 1 mg CuCl2∙2H2O). The initial pH was adjusted to 6.7 with NaOH. The medium was autoclaved (121 °C, 20 min) to remove O2 and removed from the autoclave immediately to cool under O2 free CO2. Buffer (4.0 g Na2CO3) was added after cooling. The medium was anaerobically transferred to Balch tubes (Bellco Biotechnology, Vineland, NJ, USA) or serum bottles and sealed with butyl rubber stoppers and aluminum seals prior to sterilizing in an autoclave (121 °C, 20 min). Casamino acids or Trypticase (Fisher BioReagents, Fair Lawn, NJ, USA) were prepared anaerobically, and added aseptically (15 mg mL−1). Cultures were regularly transferred in basal medium, and incubated at 39 °C for growth.
2.4. Bacterial Growth Experiments
Growth experiments were conducted with basal medium (10 mL) in Hungate tubes. Hops were added to the tubes as indicated. Each tube was inoculated (1% v/v) from an overnight culture. The growth substrate (15 mg mL−1) was peptides (Trypticase). The tubes were incubated in a shaking water bath (180 rpm) for 24 h. Growth was quantified by optical density at 600 nm in a Biowave II spectrophotometer (Biochrom, Cambridge, UK). The hops were not sterilized prior to the experiment. A control was performed by adding hops to media without inoculation, and growth did not occur over 72 h.
Clostridium sticklandii SR was obtained in 2006 from the culture collection of James B. Russell (USDA-ARS at Cornell University, Ithaca, NY, USA), and was previously described [10,11,12]. The strain is maintained in glycerol media at −80 °C in the USDA-ARS Forage-Animal Production Research Unit culture collection at University of Kentucky, Lexington, KY, USA.
2.5. Petri Plate Bioassays
Petri plate bioassays were similar to a previously described procedure [13]. Basal medium agar (1.5% w/v) was amended with Trypticase (15% w/v) as a growth substrate and anaerobically inoculated with Clostridium sticklandii SR (1% v/v, 48 h culture) when the agar was at pouring temperature. The plates were poured in an anaerobic chamber (95% CO2, 5% H2) and allowed to set at ambient temperature (23 °C). Wells were made in the agar with a sterile glass tube, and filled with basal media (100 µL) that had been steeped (12 mg mL−1, 2 h, 23 °C) with hops. The plates were incubated (24 h, 39 °C) in the anaerobic chamber and stained with tetrazolium red (2,3,5-triphenyltetrazolium, CAS 298-96-4). The plates were set on white paper with an overhead light for photography (Canon SX20IS, Tokyo, Japan). The images were imported into iPhoto v. 9.5.1 (Apple, Inc., Cupertino, CA, USA). Default settings were used to export the image, except the sharpness and de-noise, which were set on 100% and 25%, respectively.
2.6. Rumen Microbe Suspensions
Animal husbandry and procedures were performed according to the Guide for the Care and Use of Agricultural Animals in Research and Teaching, and approved by the University of Kentucky Animal Care and Use Committee (Lexington, KY, USA). Rumen fistulated Holstein steers (approx. 275 kg, 8–10 mo.) were maintained on pasture at the University of Kentucky, Animal Research Center (Woodford County, KY, USA). The pasture was composed of cool season grasses (orchardgrass, Kentucky bluegrass, tall fescue, no legumes). The stocking rate was 0.625 head acre−1. Rumen contents were removed and sealed in insulated containers for transport to the laboratory. The digesta were squeezed through four layers of cheesecloth. The fluid was collected into centrifuge bottles and subjected to slow centrifugation (100× g, 10 min) to remove plant particles. The supernatants were transferred to new bottles and subjected to centrifugation (25,600× g, 10 min) to harvest cells. The pellets were resuspended in basal medium without a growth substrate, pooled into glass vessels (500 mL) and continuously sparged with CO2, as described by Flythe [7]. Microscopic examination indicated that the cell suspensions (3 to 5 OD, pH 6.7) were primarily prokaryote-sized cells. The cell suspensions were dispensed into Balch tubes that contained CO2. Substrates (trypticase or casamino acids, 15 mg mL−1) and pulverized hops pellets were added as indicated. The hops were not autoclaved or otherwise sterilized. The bottles were incubated in a shaking water bath (180 rpm, 39 °C). Samples were clarified by centrifugation and frozen for later analysis (−20 °C). Ammonia concentrations were determined with a colorimetric method [14]. Protein was determined by the method of Lowry et al. [15].
2.7. Replication and Statistics
Each experiment was performed three or more times. Data were entered into KaleidaGraph v4.5 (Synergy Software, Reading, PA, USA) for statistical tests and graphing. Ammonia data were analyzed by ANOVA with Tukey’s test post hoc. Pure culture growth data were analyzed by paired Student’s t-test. Differences were considered significant when p < 0.05.
3. Results
3.1. Bitter Acids in Stored Hop Pellets
Extracted hop bitter acids resolved on the HPLC column and eluted as peaks quantifiable by a UV detector (Figure 1). The bitter acid contents of the hop pellets are shown in Table 1. The Chinook had 12.3% total α-acids and 3.4% total β-acid. The Galena had slightly more than 13.4% α-acids and 8.6% total β-acid. These values were obtained by comparison to a linear equation obtained with an 8-point standard curve, but similar values were obtained when the HPLC peak areas were used in the equation recommended by the ASBC.
Figure 1.
Bitter acid profiles of stored Galena (A) and Chinook (B) hops. Extracted samples were separated on a C18 column using a water-methanol-phosphoric acid mobile phase. Eluting compounds were detected at 314 nm. The peaks shown correspond to co-humulone (1), ad-humulone + humulone (2), co-lupulone (3) and ad-lupulone + lupulone (4). Standards were injected at the beginning, middle, and end of each series of sample injections to verify shifting retention times.
Table 1.
α- and β-acid concentrations of Chinook and Galena hop pellets as given on the label (Label), determined by the ASBC equation (Section 2.2), or determined by a linear equation (Equation) generated with an 8-point standard curve (Standard Curve). Values are from 3 pooled extractions, and are given on a dry matter basis.
3.2. Inhibition of Clostridium sticklandii SR by Stored Hops
The model rumen HAB, Cl. sticklandii SR, rapidly colonized basal medium agar when peptides were present as a growth substrate. When agar Petri plates that had been incubated overnight (39 °C) were treated with 2,3,5-triphenyltetrazolium, living cells took up the dye and stained red (Figure 2). Zones of growth inhibition were caused by the addition of liquid media that had been steeped with either variety of hops (12 mg mL−1, 2 h, 23 °C) to wells in the agar. Control wells that held unamended media did not show inhibition. The inhibitory activity of the hop pellets was also tested in broth culture (data not shown). Hop concentrations as low as 1.5 mg mL−1 inhibited growth and ammonia production. The lowest concentration corresponded to 185 mg L−1 α- and 51 mg L−1 β-acids for Chinook, and to 201 mg L−1 α- and 129 mg L−1 β-acids for Galena. Note that this was the lowest concentration tested, not a minimum inhibitor concentration.
Figure 2.
Antimicrobial activity of stored hops against Clostridium sticklandii SR. Basal medium agar (1.5% w/v) was amended with Trypticase (15% w/v) as a growth substrate and inoculated (1% v/v, 48 h culture) at pouring temperature. The plate was poured in an anaerobic chamber (95% CO2, 5% H2) and allowed to set. Wells were made in the agar with a sterile glass tube, and filled with basal media (100 µL) that had been steeped (12 mg mL−1, 2 h, 24 °C) with Chinook (left), the media carrier only (center) or Galena hops (right). The plate was incubated (24 h, 39 °C) in the anaerobic chamber and living cells were stained with tetrazolium red (CAS 298-96-4).
3.3. Effect of Stored Hops on Ammonia Production by Mixed Rumen Microorganisms
Ammonia was produced when mixed rumen microorganisms were incubated with peptides or free amino acids (Figure 3). The addition of pulverized hop pellets inhibited ammonia production. The lowest addition (0.6 mg mL−1) tested caused ammonia production to decrease by more than half (p < 0.05), and results with 1.2 mg mL−1 were not different from those obtained with the lower hops concentration (p > 0.05). The additional protein in the hops (approximately 20% protein) confounded ammonia results when hop concentrations greater than 1.2 mg mL−1 were added (data not shown). Ammonia concentrations did not differ by variety (p > 0.05).
Figure 3.
Ammonia production by rumen microorganisms. Washed cell suspensions of uncultivated rumen microorganisms were incubated in basal medium with either Trypticase (peptides) or Casamino acids (amino acids). The ammonia concentrations after 24 h incubation (39 °C) are shown. Black and grey bars indicate added Galena and Chinook hops, respectively. Three concentrations of each hop were used; open bars indicate no hops. hatched bars indicate 0.6 mg mL−1, solid bars indicate 1.2 mg mL−1 (black hatched, Galena 0.6 mg mL−1; black solid, Galena 1.2 mg mL−1; grey hatched, Chinook 0.6 mg mL−1; grey solid, Chinook 1.2 mg mL−1). Means are shown, and error bars represent standard deviations. Ammonia production values from peptides and amino acids were not different (p = 0.85). Hops addition significantly decreased ammonia compared to the no hops controls in all cases (p < 0.05).
4. Discussion
When the hop pellets were analyzed, the α- and β-acids concentrations were similar to what was reported at packaging 5 years earlier. The pellets had been stored in sealed, nitrogen-filled, 5 kg bags under refrigeration. The results are reported on a dry matter basis using a method that is standard for forages. It is unknown if DM changed in storage, and the differences before and after drying might also include some volatile compounds. That said, these results were consistent with a recent thorough evaluation of hop metabolite stability [16]. This latter study included quantification of many flavor and aroma components of 75 hop varieties, and their stability under different storage conditions. The results showed degradation of some components and accumulation of degradation products, but the α- and β-acids were fairly stable as long as oxygen was excluded.
It was expected that the pellets would have antimicrobial activity because the α- and β-acids were still present in the pellets. Both types of bitter acids are active against Gram-positive organisms by making the membrane permeable to protons, potassium and small molecules [17]. Thus, the mechanism of action is similar to ionophores, one of the most common classes of ruminant feed antibiotics [2]. Media that was steeped with either the Galena or Chinook pellets was inhibitory to Clostridium sticklandii SR in Petri plate bioassays and broth culture. Cl. sticklandii SR is a hyper ammonia-producing bacterium (HAB) that was first isolated from a dairy cow [10]. This strict anaerobe has a classical Gram-positive cell envelope, which is susceptible to feed ionophores, like monensin. Likewise, SR is sensitive to β-acids, which cause the loss of intracellular potassium and growth inhibition [7].
The HAB occupy amino acid fermenting niches in the rumina of cattle [10,18], sheep [19] and goats [20]. They are generally non-pathogenic, but the feed amino acids that they utilize are converted to short chain fatty acids and ammonia. Some of the ammonia can be assimilated into microbial protein, which is nutritionally available to the animal host. However, most of the ammonia is absorbed, converted to urea and lost in the urine. Thus, an important feed component can be turned into an environmental contaminant. When an antimicrobial compound suppresses the HAB, rumen ammonia is reduced; less nitrogen is lost into the environment; and the ruminant host gains weight. Improvements in average daily gain and feed efficiency have been noted with both antibiotics [3] and antimicrobial plant compounds [2].
Cl. sticklandii SR is only one of the HAB that have been isolated from the rumen. A number of other species, including Cl. aminophilum and Peptostreptococcus anaerobius from both cattle and goats, are also sensitive to hops β-acids [7,21]. Pure cultures are needed to determine specific activities and mechanisms of action. However, cultured microorganisms do not represent the full diversity of the rumen, or even the full diversity of an ecological guild, like the HAB [22]. Therefore, it is prudent to test an antimicrobial against mixed microorganisms that are removed from the rumen and rapidly used ex vivo without culture. Both hop varieties suppressed ammonia production from either free amino acids or peptides by mixed rumen microorganisms that were taken from Holstein steers.
5. Conclusions
Five years of storage under nitrogen did not significantly decrease the bitter acid concentrations in either hop variety. Thus, the hops inhibited the growth of a rumen HAB in pure culture, and inhibited ammonia production by uncultivated rumen microorganisms. These results provide evidence that older hop pellets can be suitable as a bioactive ruminant feed supplement. The experiments described here were directed toward nitrogen efficiency because HAB are a focus area of our laboratory. However, hops bitter acids inhibit rumen methane production, as well [4]. Even residual hop acids in spent craft brewers’ yeast inhibited methane production [23] and ammonia production [24]. It is highly likely that older hops will also inhibit methane. Further studies with hops are warranted, and it is plausible that ruminant industries could benefit from older hops that are not wanted by brewers. It is also noteworthy that non-ruminant species, like poultry and horses, could benefit from the antimicrobial activity in hops [25,26]. Further research is needed in these species, but it is likely that non-ruminant animal industries can also utilize surplus hops.
Acknowledgments
This work was funded by the United States Department of Agriculture, Agricultural Research Service.
Author Contributions
All authors contributed to writing the manuscript. Jesse Pappas proposed to study aged hops. Brittany E. Harlow and Glen E. Aiken oversaw the animal portion of the experiments. Isabelle A. Kagan and Gloria L. Gellin performed and described analyses. Michael D. Flythe planned the experiments, performed the microbiology and was primarily responsible for writing the manuscript.
Conflicts of Interest
Jesse Pappas is co-owner of a hops exchange. The other authors have no financial interest in the research.
References
- United States Agricultural Statistics Board, National Agricultural Statistics Service. Acreage; National Agricultural Statistics Service: Washington, DC, USA, 2017; ISBN 1949-1522. Available online: http://usda.mannlib.cornell.edu/usda/current/Acre/Acre-06-30-2017.pdf (accessed on 8 January 2017).
- Flythe, M.D.; Kagan, I.A.; Wang, Y.; Narvaez, N. Hops (Humulus lupulus L.) Bitter Acids: Modulation of Rumen Fermentation and Potential as an Alternative Growth Promoter. Front. Vet. Sci. 2017, 4, 131. [Google Scholar] [CrossRef] [PubMed]
- Russell, J.B.; Strobel, H.J. Effect of ionophores on ruminal fermentation. Appl. Environ. Microbiol. 1989, 55, 1–6. [Google Scholar] [PubMed]
- Narvaez, N.; Wang, Y.; Xu, Z.; McAllister, T. Effects of hops on in vitro ruminal fermentation of diets varying in forage content. Livest. Sci. 2011, 138, 193–201. [Google Scholar] [CrossRef]
- Flythe, M.D.; Aiken, G.E. Effects of hops (Humulus lupulus L.) extract on volatile fatty acid production by rumen bacteria. J. Appl. Microbiol. 2010, 109, 1169–1176. [Google Scholar] [CrossRef] [PubMed]
- Lavrenčič, A.; Levart, A.; Košir, I.J.; Čerenak, A. Influence of two hop (Humulus lupulus L.) varieties on in vitro dry matter and crude protein degradability and digestibility in ruminants. J. Sci. Food Agric. 2013, 94, 1248–1252. [Google Scholar] [CrossRef] [PubMed]
- Flythe, M.D. The antimicrobial effects of hops (Humulus lupulus L.) on ruminal hyper ammonia-producing bacteria. Lett. Appl. Microbiol. 2009, 118, 242–248. [Google Scholar]
- Sahlstrom, A.; Rostad, S. HPLC determination of α and β acids in hops. Concordia Coll. J. Anal. Chem. 2011, 2, 78–83. [Google Scholar]
- Pedjie, N. Determination of α Acids in Hops and Beers; Application Note; Perkin Elmer: Waltham, MA, USA, 2012. [Google Scholar]
- Chen, G.J.; Russell, J.B. More monensin-sensitive, ammonia-producing bacteria from the rumen. Appl. Environ. Microbiol. 1989, 55, 1052–1057. [Google Scholar] [PubMed]
- Russell, J.B.; Strobel, H.J.; Chen, G.J. Enrichment and isolation of a ruminal bacterium with a very high specific activity of ammonia production. Appl. Environ. Microbiol. 1988, 54, 872–877. [Google Scholar] [PubMed]
- Paster, B.J.; Russell, J.B.; Yang, C.M.; Chow, J.M.; Woese, C.R.; Tanner, R. Phylogeny of the ammonia-producing ruminal bacteria Peptostreptococcus anaerobius, Clostridium sticklandii, and Clostridium aminophilum sp. nov. Int. J. Syst. Bacteriol. 1993, 43, 107–110. [Google Scholar] [CrossRef] [PubMed]
- Kagan, I.A.; Flythe, M.D. Thin-Layer Chromatographic (TLC) separations and bioassays of plant extracts to identify antimicrobial compounds. J. Vis. Exp. 2014, 85, e51411. [Google Scholar] [CrossRef] [PubMed]
- Chaney, A.L.; Marbach, E.P. Modified reagents for determination of urea and ammonia. Clin. Chem. 1962, 8, 130–132. [Google Scholar] [PubMed]
- Lowry, O.H.; Rosenbough, N.J.; Farr, A.L.; Randall, R.J. Protein measurement with the folin phenol reagent. J. Biol. Chem. 1951, 193, 265–275. [Google Scholar] [PubMed]
- Dresel, M.; Vogt, C.; Dunkel, A.; Hofmann, T. The Bitter Chemodiversity of Hops (Humulus lupulus L.). J. Agric. Food Chem. 2016, 64, 7789–7799. [Google Scholar] [CrossRef] [PubMed]
- Teuber, M.; Schmalreck, A.F. Membrane Leakage in Bacillus subtilis 169 induced by the hop constituents lupulone, humulone, isohumulone and humulinic acid. Arch. Microbiol. 1973, 94, 159–171. [Google Scholar]
- Bento, C.B.P.; De Azevedo, A.C.; Detmann, E.; Mantovani, H.C. Biochemical and genetic diversity of carbohydrate-fermenting and obligate amino acid-fermenting hyper-ammonia-producing bacteria from Nellore steers fed tropical forages and supplemented with casein. BMC Microbiol. 2015, 15, 28. [Google Scholar] [CrossRef] [PubMed]
- Eschenlauer, S.C.; McKain, N.; Walker, N.D.; McEwan, N.R.; Newbold, C.J.; Wallace, R.J. Ammonia production by ruminal microorganisms and enumeration, isolation, and characterization of bacteria capable of growth on peptides and amino acids from the sheep rumen. Appl. Environ. Microbiol. 2002, 68, 4925–4931. [Google Scholar] [CrossRef] [PubMed]
- Flythe, M.; Andries, K. The effects of monensin on amino acid catabolizing bacteria isolated from the Boer goat rumen. Small Rumin. Res. 2009, 81, 178–181. [Google Scholar] [CrossRef]
- Flythe, M.D.; Aiken, G.E.; Gellin, G.L.; Klotz, J.L.; Goff, B.M.; Andries, K.M. Hops (Humulus lupulus) ß-Acid as an Inhibitor of Caprine Rumen Hyper-Ammonia-Producing Bacteria In Vitro. Agric. Food Anal. Bacteriol. 2015, 5, 29–36. [Google Scholar]
- Krause, D.O.; Nagaraja, T.G.; Wright, A.D.G.; Callaway, T.R. Board-invited review: Rumen microbiology: Leading the way in microbial ecology. J. Anim. Sci. 2013, 91, 331–341. [Google Scholar] [CrossRef] [PubMed]
- Pszczolkowski, V.L.; Bryant, R.W.; Harlow, B.E.; Aiken, G.E.; Martin, L.J.; Flythe, M.D. Effects of spent craft brewers’ yeast on fermentation and methane production by rumen microorganisms. Adv. Microbiol. 2016, 6, 716–723. [Google Scholar] [CrossRef]
- Harlow, B.E.; Bryant, R.W.; Cohen, S.D.; O’Connell, S.P.; Flythe, M.D. Degradation of spent craft brewer’s yeast by caprine rumen hyper ammonia-producing bacteria. Lett. Appl. Microbiol. 2016, 63, 307–312. [Google Scholar] [CrossRef] [PubMed]
- Siragusa, G.R.; Haas, G.J.; Matthews, P.D.; Smith, R.J.; Buhr, R.J.; Dale, N.M.; Wise, M.G. Antimicrobial activity of lupulone against Clostridium perfringens in the chicken intestinal tract jejunum and caecum. J. Antimicrob. Chemother. 2008, 61, 853–858. [Google Scholar] [CrossRef] [PubMed]
- Harlow, B.E.; Lawrence, L.M.; Kagan, I.A.; Flythe, M.D. Inhibition of fructan-fermenting equine faecal bacteria and Streptococcus bovis by hops (Humulus lupulus L.) β-acid. J. Appl. Microbiol. 2014, 117, 329–339. [Google Scholar] [CrossRef] [PubMed]
© 2017 by the authors. Licensee MDPI, Basel, Switzerland. This article is an open access article distributed under the terms and conditions of the Creative Commons Attribution (CC BY) license (http://creativecommons.org/licenses/by/4.0/).